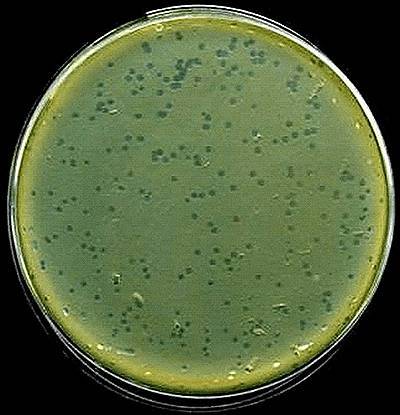

Сергей Головин. Бактериальный иммунитет: применение бактериофагов в медицине

Начало темы см. в пред. статье Сергей Головин. Враг моего врага — мой друг. Пожиратели бактерий: убийцы в роли спасителей
Казалось бы: если бактериофаги атакуют любых бактерий и их численность настолько велика (фаги — самые многочисленные вирусные формы в биосфере Земли, их общее количество — 1030–1032 фаговых частиц [21], что примерно равно количеству бактерий, 4–6×1030), то почему они до сих пор не уничтожили всех бактерий? Ответ очевиден: в процессе эволюционного соразвития бактерии выработали своего рода иммунитет против фагов.
Причем иммунитет многослойный. Во-первых, бактерия может быть изначально лишена рецепторов к тому или иному фагу или лишиться их посредством мутаций. Во-вторых, бактерия может быть иммунизирована уже «прописавшимися» в ней профагами, которые с помощью специфических репрессоров просто не дадут вновь прибывшим сородичам размножиться.
В-третьих, бактерия (или ее мобильные генетические элементы) кодирует рестрикционно-модификационные системы, которые просто рубят на кусочки нуклеиновые кислоты, не содержащие особых метильных меток — подписей «я свой».
А в-четвертых… В 2005 году стало известно, что функциональной основой бактериального иммунитета является система CRISPR [22], двумя годами позже — что для ее работы критически важен белок Cas, а в 2012-м уже появилась возможность создания инженерных систем на основе CRISPR-Cas9 Streptococcus pyogenes [23]. Работа системы CRISPR-Cas основана на том, что небольшой фрагмент, вырезанный из проникшей в бактериальную клетку фаговой ДНК, вставляется в специальный участок (локус CRISPR) генома бактерии. Каждый локус CRISPR содержит множество таких вставок (спейсеров, разделенных особыми короткими нуклеотидными повторами), представляющих собой фрагменты ДНК встреченных когда-либо фагов и плазмид.
На основе спейсеров синтезируются молекулы РНК, комплементарные соответствующему участку фагового (или плазмидного) генома. Эти РНК в комплексе с белками Cas затем опознают и обезвреживают мишень — чужеродную ДНК с комплементарной последовательностью нуклеотидов. Таким образом, если в клетку однажды проникла фаговая ДНК, но клетка выжила и встроила фрагмент чужеродного генома в свой нуклеоид, то последующие попытки таких же фагов эксплуатировать клетку или ее потомков будут неэффективны [24].
О том, как CRISPR-система из иммунной превратилась в редактирующую и служит человечеству, а также каких успехов добились другие технологии редактирования генома, читайте в статьях: «А не замахнуться ли нам на… изменение генома?» [25], «Мутагенная цепная реакция: редактирование геномов на грани фантастики» [26], «Успех в борьбе с лейкозом: на шаг ближе к клиническому применению геномного редактирования» [27]. — Ред.
Впрочем, бактериофаги за счет случайных мутаций и отбора умеют обходить системы CRISPR-Cas. Чтобы конкретный спейсер потерял эффективность, достаточно даже незначительного изменения комплементарного ему фрагмента фагового генома. Поэтому фаги успешно и довольно быстро преодолевают приобретенный иммунитет бактерий за счет точечных мутаций. С другой стороны, системы CRISPR очень широко распространены у бактерий и, судя по всему, обеспечивают своим обладателям надежную защиту.
Эффективность CRISPR обеспечивается тем, что даже две разные бактерии одного и того же штамма встраивают в свой геном разные спейсеры, соответствующие разным участкам генома фага. В результате популяция бактерий быстро приобретает генетическое разнообразие, что значительно повышает их шансы на выживание.
Точечные мутации, «обезвреживающие» один спейсер, позволят фагам заразить только небольшую часть бактериальной популяции. К тому же, бактериофаг не может определить заранее, какие спейсеры имеются у конкретной клетки. Поэтому большинство фагов в полиморфной популяции бактерий погибает даже при высокой скорости появления точечных мутаций.
Такой феномен коллективного бактериального иммунитета был продемонстрирован на бактериях P. aeruginosa и фагах DMS3vir [28]. Для начала ученые убедились, что система CRISPR действительно защищает бактерий от данной разновидности фагов, а культуры бактерий с отключенной CRISPR-системой активно этим фагом поражаются, хотя и выработали иную форму защиты: у них распространились мутации, меняющие рецептор, к которому прикрепляется фаг.
Такой способ защиты оказался менее эффективным, так как по истечении 30 суток эксперимента бактериофаги всё еще находились в популяции. Чтобы доказать, что разнообразие спейсеров системы CRISPR-Cas — основа эффективности коллективной иммунной защиты, ученые сравнили устойчивость к фагам у бактериальных популяций с разным уровнем разнообразия спейсеров.
Оказалось, что фаги в монокультурах бактерий уже в первые сутки приобретали мутации, нейтрализующие соответствующие спейсеры. У фагов же в популяциях, составленных из нескольких клонов бактерий с различными спейсерами, устойчивость формировалась лишь в немногих случаях. В популяциях, сформированных из 24–48 клонов, фаги не смогли преодолеть защиту CRISPR-Cas.
Отсюда следует, что в монокультуре единичная мутация фаговой ДНК, обеспечивающая защиту от конкретного спейсера, позволяет фагу заразить любую бактерию, а в полиморфной культуре из 48 клонов точно такая же мутация обеспечивает успех с вероятностью лишь 1/48.
Даже при условии, что ДНК фага встроится в бактерию, защиту которой он преодолел, его потомки снова столкнутся с той же проблемой, и она будет усугубляться по мере снижения численности бактерий, чувствительных к этому фагу.
Таким образом, точечные мутации и отбор — недостаточно эффективная для вирусов эволюционная стратегия, что объясняет успешность систем CRISPR-Cas и их широкое распространение у бактерий. Но тогда почему бактериофаги до сих пор не «вымерли» — раз эта система так эффективна? Не так давно у них обнаружили особые гены, подавляющие работу CRISPR [29].
А что же могут противопоставить бактерии? Ответ, опять же, в разнообразии: существует много разных вариантов системы CRISPR, каждый из которых уязвим только для некоторых анти-CRISPR-генов и защищен от других. Содержать же в своем геноме множество подобных генов бактериофаги не могут, так как отбор у них ведется преимущественно в направлении компактизации генома — в угоду увеличению скорости размножения.
Такая антагонистическая коэволюция фагов и бактерий, протекающая параллельно на разных уровнях и в разных временных масштабах (формирование новых спейсеров бактериями — точечные мутации фагов, выработка новых генов анти-CRISPR — формирование новых вариантов системы CRISPR) позволяет соблюдать баланс в системе «бактериофаг — бактерия» на уровне одной популяции и биоценоза в целом [28], [30].
Получение бактериофагов
Бактериофаги широко распространены в природе. Везде, где есть бактерии — есть фаги. Их можно выделить из открытых полостей организма человека и животных, водоемов, сточных вод, почвы, из соответствующих культур бактерий и т.д. Большое количество бактериофагов находится в выделениях больных людей и животных, особенно в период выздоровления от инфекционных заболеваний.
Таким образом, поиск и выделение новых фагов не представляет трудности. Для выделения бактериофага исследуемый материал (воду, испражнения, гной, почву и др.) засевают в жидкую питательную среду, инкубируют в термостате, и через сутки помутневшую жидкость пропускают через бумажный, а затем через бактериальный фильтры, асбестовые пластины, керамические свечи.
Полученный фильтрат исследуют на наличие бактериофага путем совместного посева с подходящей микробной культурой на плотные или в жидкие питательные среды. Если бактериофаг выделился, то после 18-часовой инкубации на поверхности агара вырастает сплошной газон культуры с прозрачными бляшками — зонами лизиса (рис. 12). В бульоне бактериофаг обусловливает просветление среды.
Для выделения чистой культуры бактериофага материал из отдельной бляшки переносят бактериологической иглой в суспензию молодой микробной культуры.
Материал из вновь возникшего стерильного пятна засевают вместе с фагочувствительными микробами в жидкую питательную среду. После 6–18 часов инкубации среду фильтруют и получают чистую культуру бактериофага.
Для изготовления серийного препарата бактериофага применяют только апробированные штаммы и культуры микробов, обладающие типичными морфологическими, биохимическими и серологическими свойствами. Штаммы бактериофагов должны быть музейными и рабочими.
Музейные производственные штаммы ежегодно обновляются путем выделения новых или пассажами имеющихся фаговых штаммов через организм больного, а также адаптацией к свежевыделенным, резистентным к данному бактериофагу культурам.
Промышленное получение бактериофага в настоящее время осуществляют в специальных аппаратах — реакторах емкостью 250–1000 л, с применением аэрации как фактора, стимулирующего развитие микроорганизмов. В реактор наливают жидкую питательную среду, которую стерилизуют при температуре 110 °С в течение 40 минут.
После стерилизации среду охлаждают до 39 °С и засевают соответствующей микробной культурой и бактериофагом одновременно. Для засева используют 18-часовые агаровые культуры, которые прибавляют из расчета 50 млн микробных клеток на миллилитр среды. Бактериофаг добавляют в количестве не более 0,3 % по отношению к объему питательной среды.
Среду с бактериальной культурой и фагом оставляют при температуре 37 °С на 6–18 часов. Фаги активно размножаются внутри бактериальных клеток и вызывают их лизис, что внешне проявляется полным просветлением среды. К полученному лизату добавляют в качестве консерванта хинозол (0,01 %) или фенол (0,25 %) и не позже чем через два часа после этого фильтруют содержимое реактора через бактериальные фильтры для удаления оставшихся микробных клеток.
Полученный препарат бактериофага должен иметь вид совершенно прозрачной жидкости желтого цвета. Он проходит контроль на стерильность, безвредность и литическую активность. Безвредность препарата проверяют путем введения животным. Например, брюшнотифозный и дизентерийный бактериофаги вводят подкожно трем мышам по 1 мл, либо внутривенно одному кролику 5 мл.
За животными наблюдают в течение 3–4 суток. Литическую активность бактериофага определяют титрованием в жидкой питательной среде методом Аппельмана, на плотной питательной среде — методом Отто. За титр бактериофага при определении методом Аппельмана принимают то его наибольшее разведение, которое вызывает полный лизис тестовой культуры микроорганизмов.
После проведения контрольных исследований препарат разливают во флаконы нейтрального стекла. Помимо жидких препаратов бактериофага могут изготавливать и сухие. Для их получения фаголизат осаждают сернокислым аммонием, осадок отделяют от жидкой части, добавляют к нему стабилизатор (9 % глюконат кальция), смесь тщательно растирают и лиофилизируют [31].
Биологическое значение бактериофагов
Бактериофаги играют важную роль в круговороте углерода и энергии, контроле численности микробных популяций и эволюции бактерий. Бактериофаги, будучи подвижными генетическими элементами, служат мощным фактором изменчивости бактерий.
Например, они осуществляют процесс трансдукции — перенос бактериальных генов из одной клетки в другую: вырезаясь из генома одной бактерии, они могут прихватывать с собой в капсид ее гены и, инфицируя другую клетку, передавать их новому хозяину.
Есть все основания предполагать, что большинство бактерий содержит профаги. Многие культуры несут 2–4 и даже более умеренных фагов, то есть являются полилизогенными. Например, многие актиномицеты и клубеньковые бактерии содержат в геноме четырех и более профагов.
Способность фагов менять фенотип бактерий путем привнесения чужеродных (и фаговых в том числе) генов может быть одновременно залогом процветания для бактерий и источником больших проблем для человечества: так бактерии могут приобретать факторы вирулентности и устойчивости — к другим фагам, антибиотикам и прочим воздействиям (если фаг, например, награждает бактерию способностью формировать биопленки) [32].
В 1951 году была описана фаговая конверсия Corinebacterium diphtheriae: оказалось, что ген tox, кодирующий дифтерийный токсин, в геном нетоксигенных бактериальных штаммов привносится умеренным фагом β. В результате коринебактерия производит сильнейший токсин, инактивирующий в человеческих клетках один из компонентов трансляционного аппарата — EF-2 (эукариотический фактор элонгации
2). Подавление синтеза белка проявляется своеобразной дифтерийной симптоматикой. Аналогичные механизмы приобретения патогенных свойств позже выявили у холерных вибрионов, сальмонелл, клостридий и др.
Лабораторное и промышленное применение бактериофагов
Способность фагов к внесению в клетку определенного количества генетического материала, упакованного в капсид, широко эксплуатируется в генной инженерии: их часто используют в качестве векторов различного назначения. Например, для создания библиотек генов нередко конструируют векторы на основе бактериофага λ, содержащего двухцепочечную ДНК.
Левое и правое плечи ДНК фага содержат гены, необходимые для литического цикла, а среднюю — несущественную для размножения — часть молекулы можно заменять крупным (примерно до 24 т.п.н.) фрагментом чужеродной ДНК, включая эукариотическую. Такую рекомбинантную ДНК упаковывают в вирионы и заражают ими подходящую культуру бактерий, которая затем многократно воспроизводит фаговую ДНК с интересующими человека фрагментами.
Из-за высокой специфичности многие фаги служат диагностическими инструментами для идентификации бактериальных культур в медицинской, ветеринарной, технической микробиологии и фитопатологии. Метод фаготипирования, основанный на исключительной специфичности определенных фаговых штаммов, позволил распределить на фаготипы ряд штаммов бактерий, неотличимых друг от друга по другим признакам.
Фаготипирование с успехом применяют для идентификации типов кишечной палочки, сальмонелл (включая возбудителя брюшного тифа), стафилококков и др. Этот метод дает эпидемиологам возможность отследить цепочку случаев заболевания и определить источник инфекции.
Бактериофаги прекрасно подходят для быстрого обнаружения небольших количеств патогенных бактерий во внешней среде: появляются и множатся хозяева — нарастает титр специфического бактериофага. Определение колифагов стало одним из ключевых мероприятий в санитарном контроле вод, поскольку позволяет выявить фекальное загрязнение даже при малом количестве кишечной палочки, не определяемом бактериологическими методами.
Фаги применяются и в борьбе с бактериальными вредителями различных технических брожений, и в производстве ферментов с помощью бактериальных культур. В то же время, заражая промышленные культуры, бактериофаг вредит «полезным» производственным штаммам (вакцинным, продуцентам антибиотиков, возбудителям молочнокислого, ацетонобутилового и некоторых других брожений), чем вызывает серьезные нарушения технологического процесса.
Применение бактериофагов в медицине
Первый отчет об успешной фаготерапии был опубликован в 1921 году фламандцами Р. Бранохе и Ж. Майсином, которые использовали бактериофаг для лечения кожной стафилококковой инфекции [33].
Как уже было упомянуто, западная медицина c середины ХХ века практически отказалась от использования бактериофагов в терапевтических целях [5], однако в СССР фаги довольно широко применялись. Одним из самых, пожалуй, масштабных примеров практического применения фагов является использование комплексного препарата бактериофагов в Сталинграде во время Великой Отечественной войны.
З.В. Ермольева во время работы в Ташкентском институте вакцин и сывороток разработала препарат, содержащий 19 видов бактериофагов, в том числе холерный, брюшнотифозный и дифтерийный. Во время Сталинградской битвы в связи с угрозой эпидемии холеры было налажено производство холерного фага в самом Сталинграде, и препарат ежедневно принимали около 50 тысяч человек [34].
После войны в СССР приступили к промышленному производству фаговых препаратов, которое действует и в настоящее время. В России производством бактериофагов занимаются в основном филиалы НПО «Микроген»: «Иммунопрепарат» (г. Уфа), «ИмБио» (г. Нижний Новгород), «Биомед» (г. Пермь).
На данный момент в РФ зарегистрировано и производится 13 фаговых препаратов (табл. 2).
Таблица 2. Препараты бактериофагов, выпускаемые в РФ. Таблица составлена на основе информации с сайта производителя

* Производитель предупреждает, что препараты должны применяться после оценки чувствительности возбудителей болезни к фагам, что означает еще и необходимость идентификации бактерии-возбудителя. Кроме того, в случае тяжелых инфекций фаготерапия допустима только как часть комплексного лечения
Отдельно стоит осветить вопрос применения фаготерапии в странах Запада. Как известно, после открытия антибиотиков работы, связанные с медицинским применением фагов, там были полностью свернуты.
Однако в последние годы в связи с тревожной динамикой распространения внутрибольничных инфекций, резистентных к большинству известных антибиотиков, многие биотехнологические компании сделали резкий поворот к изучению возможности создания лекарств на основе бактериофагов.
Однако, несмотря на существенные технологические преимущества, для создания эффективных препаратов необходима коллекция бактериофагов, действующих на клинически значимые штаммы возбудителей, и соответствующий опыт их клинического применения, чем эти компании пока не обладают.
В начале 2000-х Гленн Моррис, сотрудник Мэрилендского университета, совместно с НИИ бактериофагов, микробиологии и вирусологии в Тбилиси начал испытания фаговых препаратов для получения лицензии на их применение в США. В итоге в 2006 году использование бактериофагов в США было одобрено — в качестве пищевой антилистерийной добавки (спрей для обработки мяса), а вице-президент США Альберт Гор назвал их «новым оружием для борьбы с болезнетворными бактериями».
В некоторых штатах фаготерапию разрешено применять натуропатам или же в качестве дополнительного метода в комплексном лечении, например, ран [35], [36]. В настоящее время на Западе проходят доклинические испытания ряда препаратов природных и генетически модифицированных штаммов бактериофагов, активных в отношении таких коварных бактерий, как Clostridium difficile и Pseudomonas aeruginosa, правда, выход препаратов в продажу планируется только к 2023 году [37]. Есть информация и о прохождении клинических испытаний фаговых препаратов [38].
С терапевтической целью бактериофаги применяют, например, в России, Грузии и Польше, причем самыми разными способами. Для коррекции кишечных дисбиозов жидкие препараты применяют внутрь или per rectum при помощи клизмы. Таблетированные формы принимают внутрь, возможно использование бактериофагов и в составе ректальных свечей.
При кожных и раневых инфекциях их применяют в виде примочек на очаги поражения. При фарингитах, ларингитах и тонзиллитах препараты используют для орошения или полосканий, при отитах — закапывают в уши. Для лечения абсцессов в их полость вводят ватный шарик, пропитанный препаратом. Больным, страдающим хроническими остеомиелитами, препарат вводят непосредственно в пораженный участок кости.
Также препараты можно вносить в брюшную, плевральную и суставные полости, а также применять в форме аэрозолей при поражениях легких. При инфекциях мочевыводящих путей бактериофаги вливают непосредственно в пораженный орган с помощью зонда. При гинекологических заболеваниях препарат вливают в матку либо применяют влагалищные тампоны, пропитанные фаговым раствором.
А еще их используют в методике под названием фаговый дисплей, которая, в частности, позволяет находить новые антитела для диагностики и терапии заболеваний: «Враг моего врага — мой друг. Как бактерии и вирусы помогают создавать антитела для лечения человека» [39]. — Ред.
Преимущества бактериофагов перед антибиотиками достаточно очевидны.
- Способны уничтожать бактерий, устойчивых к антибиотикам и защищенных биопленками.
- Свободно проникают в кровь и лимфу и выводятся через почки с мочой. Как показано в ряде исследований, после приема 30 мл бактериофага уже через два часа фаговые частицы обнаруживают в моче, их концентрация в ней достигает максимума спустя 6–8 часов после приема [40], [41].
- Не вызывают побочных эффектов и аллергии. Все случаи аллергических реакций при использовании терапевтических бактериофагов были вызваны либо примесями, от которых препарат был недостаточно очищен, либо токсинами, выделяющимися при массовой гибели бактерий (такое явление — реакция Яриша-Герксгеймера— может наблюдаться и при применении антибиотиков).
- Не подавляют рост нормофлоры, не ослабляют иммунитет.
- Подходят для пациентов любого возраста, нет противопоказаний.
- Можно применять как в виде монотерапии, так и в сочетании с антибиотиками, что значительно снижает риск селекции резистентных штаммов бактерий.
- Можно использовать для санации лечебно-профилактических учреждений и для борьбы с госпитальными инфекциями.
- Можно применять для предупреждения инфекционных болезней в эпидемических очагах —вводить лицам с высоким риском заражения и имевшим контакт с больными.
К сожалению, недостатков бактериофаги тоже не лишены.
- Каждый бактериофаг инфицирует только строго определенный вид бактерий или даже определенный штамм, что требует проведения бактериологического исследования биологического материала больного с целью фаготипирования, а следовательно, отсрочивает начало фаготерапии; и хотя в последнее время разрабатываются ускоренные методики определения фаготипа с помощью ПЦР или масс-спектрометрии, внедряются они медленно из-за высокой стоимости и требований к квалификации специалистов.
- Для поддержания активности бактериофаги требуют особых условий хранения и транспортировки.
- Бактериофаги не действуют на внутриклеточных микроорганизмов.
- Многие бактериофаги инактивируются в условиях низкого рН желудка при пероральном применении препаратов, а также ингибируются неспецифическим действием различных факторов в жидкостях организма.
Заключение
Прошло уже 100 лет с момента открытия бактериофагов. Неоправданно забытые на Западе и чудом сохранившиеся в России, они полвека пребывали в тени успеха антибиотиков. Но эпоха триумфа антибиотиков выявила и важнейшую проблему их активного применения — угрожающий рост резистентности к ним среди опасных патогенов, и многие ученые и врачи видят именно в фагах альтернативу антибиотикам.
Если на сегодняшний день мы имеем штаммы бактерий, устойчивые даже к антимикробным препаратам «последней надежды», то фаги, благодаря описанным выше механизмам коэволюции с бактериями, никогда не утратят актуальности.
100 лет они были детально изучены, признаны безопасными и стали незаменимым инструментом в генетике и биоинженерии, санитарной микробиологии и эпидемиологии, промышленности, медицине и даже в космической сфере (да-да, бактерии с профагом используют для оценки защиты обшивки космических кораблей от радиации).
И как нельзя лучше характеризует значение фагов для человека древняя пословица: «Враг моего врага — мой друг».
Подписывайтесь нa наш телеграм-канал @history_eco https://t.me/history_eco
См. еще:
Глубоководные микробы из Арктики могут содержать антибиотики нового поколения
Sergius. У истоков вакцин и вирусологии стояли масоны
Sergius. На пути к новой нормальности. Вирусная теория: забота о здоровье или путь к сокращению популяции?
- бактериофаг, бактерии, микробиологи
Leave a reply
Для отправки комментария вам необходимо авторизоваться.